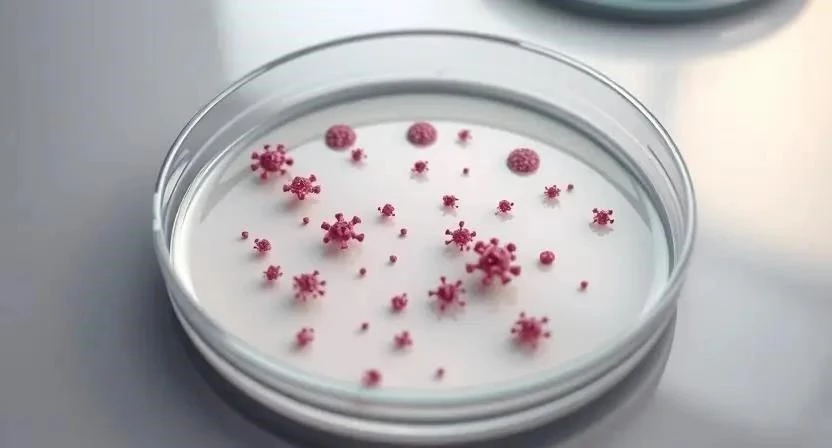

Задумывались ли вы, почему так часто мы сталкиваемся с простудами и гриппом? Вирусные инфекции – это одна из самых распространенных проблем со здоровьем, с которой сталкивается каждый человек. Ежегодно миллионы людей во всем мире болеют различными вирусными заболеваниями, что приводит к значительным экономическим потерям и снижению качества жизни. Ключевое слово в этой статье – вирусные инфекции. Давайте разберемся, что это такое, как защититься от них и что делать, если заражение все же произошло.
Вирусные инфекции: Определение, виды, классификация
Вирусные инфекции – это заболевания, вызываемые вирусами, микроскопическими инфекционными агентами, которые размножаются только внутри живых клеток. Вирусы поражают различные органы и системы организма, вызывая широкий спектр симптомов. Существует множество видов вирусных инфекций, которые классифицируются по типу вируса, способу передачи и поражаемым органам. К основным видам относятся респираторные вирусные инфекции (ОРВИ, грипп), кишечные инфекции, герпетические инфекции, гепатиты и многие другие. Классификация вирусных инфекций помогает врачам правильно диагностировать заболевание и назначать эффективное лечение.
Наиболее распространенные вирусные инфекции
Среди наиболее распространенных вирусных инфекций выделяют:
- ОРВИ (острые респираторные вирусные инфекции): Это группа инфекций, поражающих верхние дыхательные пути. Симптомы включают насморк, кашель, боль в горле, слабость и повышение температуры.
- Грипп: Более тяжелая респираторная инфекция, чем ОРВИ, характеризующаяся высокой температурой, сильной слабостью, головной болью и мышечными болями.
- Метапневмовирус: Вирус, вызывающий инфекции дыхательных путей, особенно у детей. Симптомы схожи с ОРВИ и гриппом.
- Менингококковая инфекция: Тяжелое инфекционное заболевание, поражающее мозговые оболочки и вызывающее менингит или сепсис.
- Инфекции уха: Вирусные инфекции среднего уха часто возникают как осложнение ОРВИ или гриппа.
Я помню, как в детстве каждый год болел гриппом. Мама всегда говорила, что нужно пить много жидкости и отдыхать. Тогда я не понимал, насколько это важно, но сейчас, когда сам стал отцом, стараюсь следовать этим советам.
Симптомы вирусных инфекций
Симптомы вирусных инфекций могут варьироваться в зависимости от типа вируса и индивидуальных особенностей организма. Общие симптомы включают:
- Повышение температуры тела
- Слабость и утомляемость
- Головная боль
- Мышечные боли
- Кашель
- Насморк
- Боль в горле
- Тошнота и рвота (при кишечных инфекциях)
Специфические признаки, которые могут помочь отличить одну инфекцию от другой:
- Грипп: Внезапное начало, высокая температура, сильная слабость, ломота в теле.
- ОРВИ: Постепенное начало, умеренная температура, насморк, боль в горле.
- Менингококковая инфекция: Высокая температура, головная боль, ригидность затылочных мышц, сыпь.
- Инфекции уха: Боль в ухе, снижение слуха, выделения из уха.
Однажды у меня сильно заболело горло, и я подумал, что это обычная простуда. Но через несколько дней появилась высокая температура и сильная слабость. Оказалось, что это был грипп. Я понял, что не стоит недооценивать симптомы и при необходимости нужно обращаться к врачу.
Диагностика вирусных инфекций
Диагностика вирусных инфекций включает сбор анамнеза, физический осмотр и лабораторные исследования. К основным методам лабораторной диагностики относятся:
- Общий анализ крови: Позволяет оценить общее состояние организма и выявить признаки воспаления.
- ПЦР-диагностика: Обнаружение генетического материала вируса в биологических жидкостях (кровь, мазок из носоглотки).
- Серологические тесты: Определение антител к вирусу в крови.
Когда обращаться к врачу? Необходимо обратиться к врачу при высокой температуре, сильной слабости, затрудненном дыхании, головной боли, ригидности затылочных мышц, сыпи и других тревожных симптомах. Самолечение может быть опасным и привести к осложнениям.
Лечение вирусных инфекций
Лечение вирусных инфекций зависит от типа вируса и тяжести заболевания. Существуют противовирусные препараты, которые могут подавлять размножение вируса и сокращать продолжительность болезни. Однако, не для всех вирусных инфекций существуют эффективные противовирусные препараты.
Симптоматическое лечение направлено на облегчение симптомов и улучшение самочувствия. Оно включает:
- Постельный режим
- Обильное питье
- Жаропонижающие препараты
- Обезболивающие препараты
- Противокашлевые препараты
- Сосудосуживающие капли в нос
Народные средства, такие как чай с медом и лимоном, ингаляции с эфирными маслами, полоскание горла солевым раствором, могут помочь облегчить симптомы и ускорить выздоровление.
Профилактика вирусных инфекций
Профилактика вирусных инфекций включает:
- Вакцинация: Вакцинация является наиболее эффективным способом защиты от многих вирусных инфекций, таких как грипп, корь, краснуха, паротит.
- Укрепление иммунитета: Здоровый образ жизни, правильное питание, достаточный сон, физическая активность помогают укрепить иммунитет и повысить устойчивость организма к инфекциям.
- Гигиена: Регулярное мытье рук с мылом, использование антисептиков, проветривание помещений, избегание контакта с больными людьми помогают предотвратить распространение вирусных инфекций.
Вирусные инфекции у детей
Вирусные инфекции у детей протекают особенно тяжело, так как иммунная система детей еще не полностью сформирована. Особенности течения вирусных инфекций у детей:
- Высокая температура
- Быстрое развитие симптомов
- Риск развития осложнений (отит, бронхит, пневмония)
Лечение вирусных инфекций у детей должно проводиться под контролем врача. Нельзя давать детям антибиотики без назначения врача, так как они не эффективны против вирусов.
Осложнения вирусных инфекций
Осложнения вирусных инфекций могут включать:
- Пневмония
- Бронхит
- Отит
- Менингит
- Энцефалит
- Сепсис
Как избежать осложнений? Своевременное обращение к врачу, соблюдение рекомендаций врача, полноценный отдых, обильное питье и правильное питание помогают избежать осложнений.
FAQ
Вопрос: Можно ли лечить вирусные инфекции антибиотиками?
Ответ: Нет, антибиотики не эффективны против вирусов. Они используются только для лечения бактериальных инфекций.
Вопрос: Как часто нужно мыть руки?
Ответ: Рекомендуется мыть руки с мылом не менее 20 секунд после посещения общественных мест, перед едой, после кашля или чихания.
Вопрос: Какие продукты помогают укрепить иммунитет?
Ответ: Продукты, богатые витамином C (цитрусовые, киви, шиповник), витамином D (жирная рыба, яйца), цинком (мясо, орехи, семена), пробиотиками (йогурт, кефир) помогают укрепить иммунитет.
Я всегда стараюсь придерживаться здорового образа жизни и регулярно заниматься спортом. Это помогает мне оставаться здоровым и избегать вирусных инфекций. Надеюсь, мои советы помогут и вам!
Таблица 1: Симптомы различных вирусных инфекций
| Инфекция | Температура | Кашель | Насморк | Слабость | Другие симптомы |
|---|---|---|---|---|---|
| ОРВИ | Умеренная (37-38°C) | Сухой или влажный | Выраженный | Умеренная | Боль в горле, головная боль |
| Грипп | Высокая (38-40°C) | Сухой, мучительный | Слабый | Сильная | Ломота в теле, головная боль |
| Метапневмовирус | Высокая (38-39°C) | Сухой, приступообразный | Выраженный | Умеренная | Затрудненное дыхание |
| Менингококковая инфекция | Высокая (39-40°C) | Отсутствует | Отсутствует | Сильная | Ригидность затылочных мышц, сыпь |
Таблица 2: Методы профилактики вирусных инфекций
| Метод | Описание | Эффективность | Примечания |
|---|---|---|---|
| Вакцинация | Высокая | Необходима регулярная ревакцинация | |
| Мытье рук | Регулярное мытье рук с мылом | Средняя | Необходимо мыть руки не менее 20 секунд |
| Использование антисептиков | Обработка рук антисептическими средствами | Средняя | Эффективно в отсутствие возможности помыть руки |
| Проветривание помещений | Регулярное проветривание помещений | Средняя | Обеспечивает приток свежего воздуха |
Таблица 3: Препараты для лечения вирусных инфекций
| Препарат | Действующее вещество | Показания | Противопоказания |
|---|---|---|---|
| Тамифлю | Осельтамивир | Грипп A и B | Индивидуальная непереносимость |
| Ремантадин | Ремантадин | Грипп A | Индивидуальная непереносимость, заболевания почек |
| Интерферон | Интерферон альфа | ОРВИ, грипп | Индивидуальная непереносимость, аутоиммунные заболевания |








